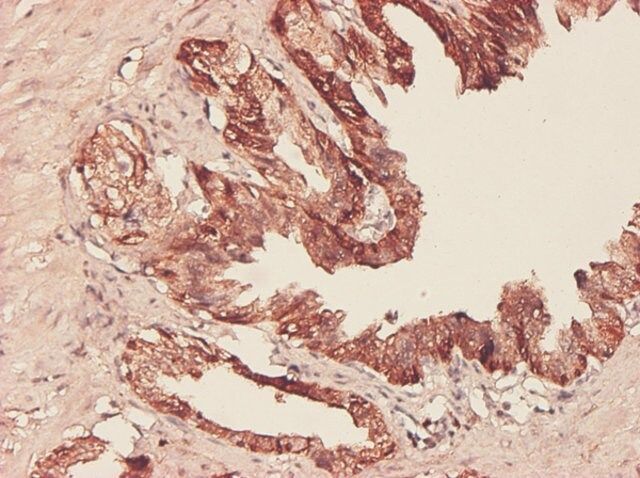

产品说明
免疫原
PHGDH (AAH11262.1, 1 a.a. ~ 533 a.a) full-length recombinant protein with GST tag. MW of the GST tag alone is 26 KDa.
Sequence
MAFANLRKVLISDSLDPCCRKILQDGGLQVVEKQNLSKEELIAELQDCEGLIVRSATKVTADVINAAEKLQVVGRAGTGVDNVDLEAATRKGILVMNTPNGNSLSAAELTCGMIMCLARQIPQATASMKDGKWERKKFMGTELNGKTLGILGLGRIGREVATRMQSFGMKTIGYDPIISPEVSASFGVQQLPLEEIWPLCDFITVHTPLLPSTTGLLNDNTFAQCKKGVRVVNCARGGIVDEGALLRALQSGQCAGAALDVFTEEPPRDRALVDHENVISCPHLGASTKEAQSRCGEEIAVQFVDMVKGKSLTGVVNAQALTSAFSPHTKPWIGLAEALGTLMRAWAGSPKGTIQVITQGTSLKNAGNCLSPAVIVGLLKEASKQADVNLVNAKLLVKEAGLNVTTSHSPAAPGEQGFGECLLAVALAGAPYQAVGLVQGTTPVLQGLNGAVFRPEVPLRRDLPLLLFRTQTSDPAMLPTMIGLLAEAGVRLLSYQTSLVSDGETWHVMGISSLLPSLEAWKQHVTEAFQFHF
应用
Monoclonal Anti-PHGDH antibody produced in mouse has been used in Western Blotting.
生化/生理作用
The gene PHGDH (D-3-phosphoglycerate dehydrogenase) is mapped to human chromosome 1p. The enzyme is mainly responsible for catalyzing initial step of the serine synthesis pathway, converting 3-phosphoglycerate into 3-phosphohydroxypyruvate. It is up-regulated in estrogen receptor-negative breast cancers, melanoma and cervical cancers. Mutations in the gene encoding PHGDH are associated with Neu-Laxova syndrome. Down-regulation in PHGDH levels results in congenital microcephaly, psychomotor retardation and seizures.
外形
Solution in phosphate buffered saline, pH 7.4
法律信息
GenBank is a registered trademark of United States Department of Health and Human Services
免责声明
Unless otherwise stated in our catalog or other company documentation accompanying the product(s), our products are intended for research use only and are not to be used for any other purpose, which includes but is not limited to, unauthorized commercial uses, in vitro diagnostic uses, ex vivo or in vivo therapeutic uses or any type of consumption or application to humans or animals.
基本信息
| NACRES | NA.41 |
产品性质
| 质量水平 | 100 |
| 生物来源 | mouse |
| 偶联物 | unconjugated |
| 抗体形式 | purified immunoglobulin |
| antibody product type | primary antibodies |
| 克隆 | 4A3-1D6, monoclonal |
| 形式 | buffered aqueous solution |
| species reactivity | human |
| technique(s) | immunohistochemistry (formalin-fixed, paraffin-embedded sections): suitable immunoprecipitation (IP): suitable indirect ELISA: suitable indirect immunofluorescence: suitable western blot: 1-5 μg/mL |
| 同位素/亚型 | IgG1κ |
| GenBank® accession no. | BC011262 |
| UniProt登记号 | O43175 |
| 运输 | dry ice |
| 储存温度 | −20℃ |
| Gene Information | human ... PHGDH(26227) |
安全信息
| 储存分类代码 | 12 - Non Combustible Liquids |
| 闪点(F) | Not applicable |
| 闪点(C) | Not applicable |
| 个人防护装备 | Eyeshields, Gloves, multi-purpose combination respirator cartridge (US) |